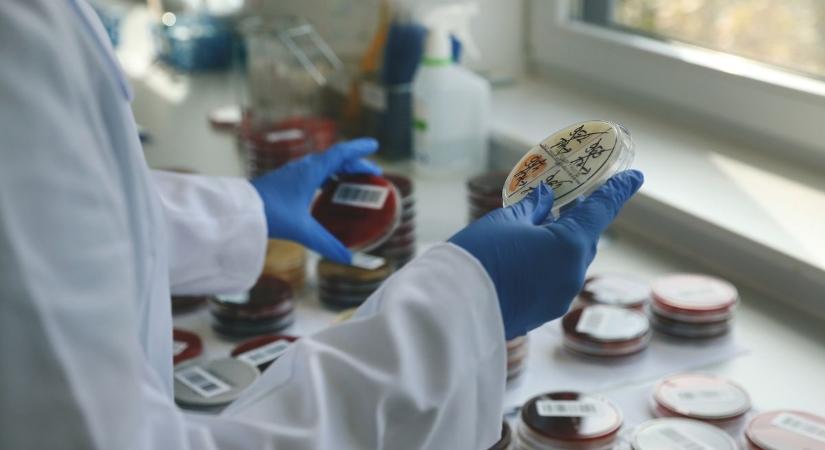
Amilyen ijesztő a neve, olyan szörnyű ez a fertőzés – több hajdú-bihari betegnél is kimutatták

Amilyen ijesztő a neve, olyan szörnyű ez a fertőzés – több hajdú-bihari betegnél is kimutatták
Mutatjuk, hogyan alakult a fertőző betegségek száma február derekán.

Hamarosan átirányítunk a teljes cikkhez → Haon
Mutatjuk, hogyan alakult a fertőző betegségek száma február derekán.
Hamarosan átirányítunk a teljes cikkhez → Haon